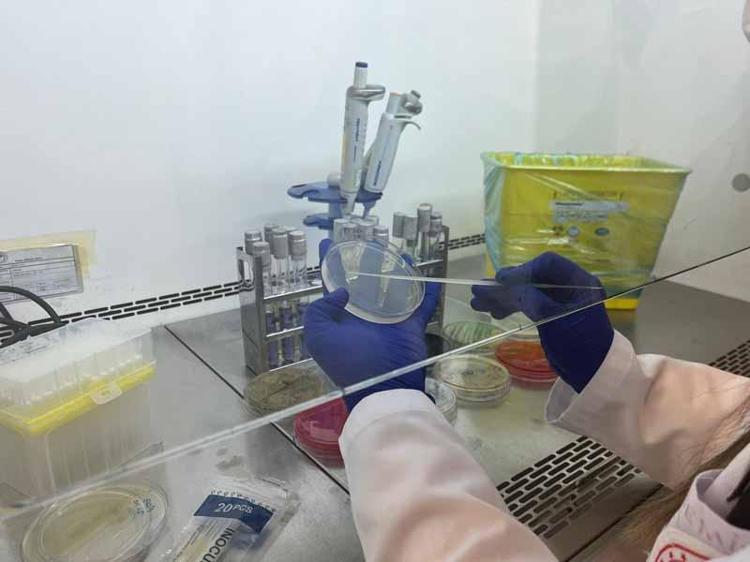
YURT DIŞINA DA HİZMET VERİYORUZ
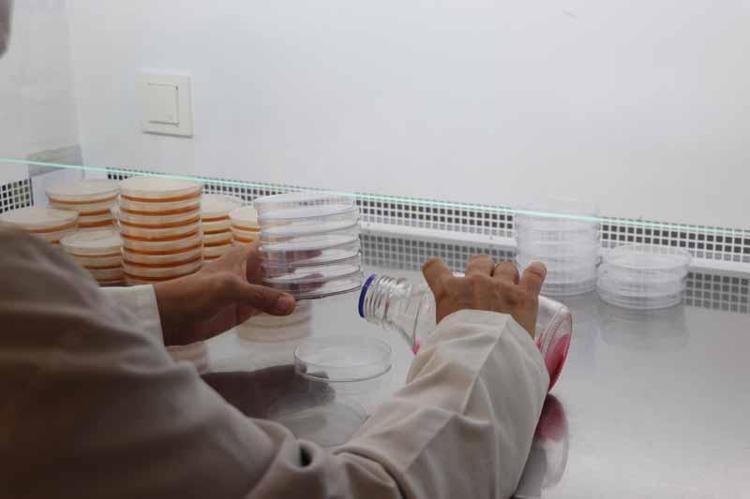
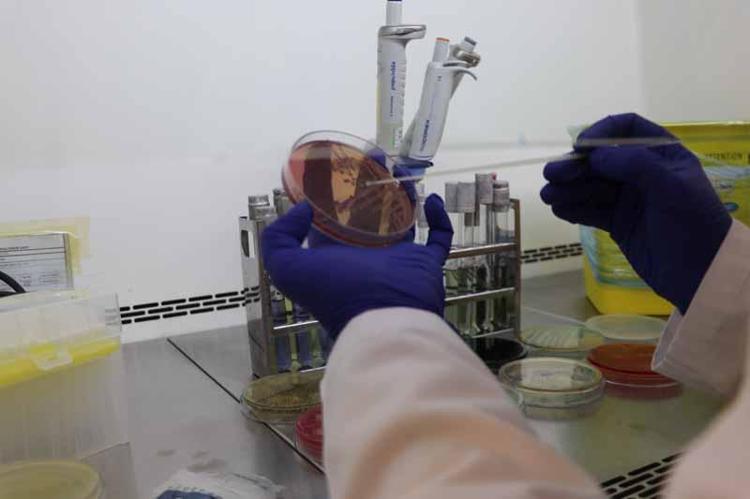

Ankara'da yılda 1 milyon 800 bin gıda analizi
Tarım ve Orman Bakanlığı'na bağlı Ankara Gıda Kontrol Laboratuvarı'nda, yılda yaklaşık 1 milyon 800 bin gıda analizi yapılıyor.

Tarım ve Orman Bakanlığı, gıda denetimleri sonucunda ortaya çıkan uygunsuzlukları, bakanlığın web sitesinde yer alan ‘Gıda Kamuoyu Duyurusu Sistemi'nde ilan ediyor. 17 Aralık 2011 tarihli Gıda ve Yemin Resmi Kontrolüne Dair Yönetmeliğin 8'inci maddesi gereğince kişilerin hayatını ve sağlığını tehlikeye düşürecek şekilde bozulmuş, değiştirilmiş gıdaları üreten veya satan firmaların adı, ürün adı, markası, parti ve seri numarası burada paylaşılıyor. Yapılan denetimlerde alınan numuneler, Gıda Kontrol Laboratuvar Müdürlüğü'nde inceleniyor. Laboratuvar ortamında numunelerin uygun olup olmadığı tespit ediliyor. Ankara Gıda Kontrol Laboratuvar Müdürlüğü dahil ülke genelinde 41 laboratuvarda yapılan analizler sonucu tespit edilen uygunsuz gıdalar önce piyasadan toplanıyor, sonrasında ise satışa uygun olmayan gıdayı satan iş yerlerine ilgili mevzuat kapsamında ceza uygulanıyor.
'HER BİR NUMUNE BAKROTLANDIRILIYOR'
Ankara Gıda Kontrol Laboratuvar Müdürü Yusuf Varlık, il ve ilçe tarım müdürlükleri gıda denetçileri tarafından alınan numunelerin, soğuk zincir korunarak numune kabul birimlerine getirildiğini ifade ederek, "Bakanlığımızın yazılımı olan Gıda Kontrolü Laboratuvar Sistemi'ne kayıtlar gerçekleştiriliyor. Yazılıma kaydedilen her bir numune barkot verilerek, hızlı bir şekilde içinde bulunduğumuz laboratuvarlara sevkleri yapılıyor. Laboratuvara getirilen numunelerin önce homojenizasyonu ve ardından tartımı yapıldıktan sonra burada kontrollü şartlarda bakterinin üreyebileceği uygun ortamlarda 24 ve 48 saat içinde analiz yaparak raporlandırılıyor" dedi.
'YURT DIŞINA DA HİZMET VERİYORUZ'
Varlık, yurt içinde verdikleri analiz hizmetinin yanı sıra yurt dışına da hizmet verdiklerini belirterek, "Yurt dışında şu anda Polonya, Kuzey İrlanda, Kuzey Kıbrıs Türk Cumhuriyeti, Azerbaycan, Kazakistan ve Hindistan gibi ülkelere de analiz hizmeti gerçekleştiriyoruz. Biz çalışmalarımızı daha fazla ülkeye yaymak için çabalıyoruz. Bu anlamda laboratuvarımız dünyanın en büyük laboratuvarlarından biridir. Burada analizi yapılan numunede herhangi bir uygunsuzluk varsa tarafımızca hazırlanan rapor, il müdürlüğüne düşer, 7 gün içinde ilgili firmaya 'şahit' ve 'itiraz' hakkını kullanması için yazı gönderilir. İtiraz hakkını kullanmak isteyen firma da bakanlığımızın farklı bir laboratuvarına gönderilerek tekrar orada analizi yapılır. Orada da yine 'uygun değil' çıkarsa ceza işlemleri; idari para cezası veya ürünlerin toplatılması gibi yaptırımları il ve ilçe müdürlüklerimiz tarafından yapılır" ifadelerini kullandı.

'12 BİN NUMUNEDE ANALİZ YAPTIK'
Laboratuvarının 23 bin 517 metrekare alana sahip olduğunu, 16 laboratuvar birimleri bulunduğunu aktaran Varlık, "Analizlerimiz, 190 personel tarafından ve donanımlı cihazlarda yapılıyor. Personelimiz yıllık 23 bin numunede yaklaşık 1 milyon 800 bin analiz gerçekleştiriyor. Bu yıl şu ana kadar 12 bin numunede analiz gerçekleştirdik. Bu yıl sonuna kadar 15 bin numune sayısına ulaşacağımızı düşünüyorum. Laboratuvar olarak dünyada ilk 3'e girebilecek büyüklükte ve donanıma sahip olduğumuzu söyleyebilirim. Dünyada olan bütün cihazlar hemen hemen burada mevcut. Hatta pek çok Avrupa ülkesinden daha üstün teknoloji cihazlarını da analizlerimizde kullanmaktayız" değerlendirmesinde bulundu.

‘GÜNDE 150-200 ARASINDA NUMUNE GELİYOR’
Varlık, günde ortalama 150-200 arasında numunenin geldiğini söyleyerek, "Ağırlıklı olarak mikrobiyolojik analizlerimiz çok fazla. Yine pestisit analizlerimiz var. Bunun yanında ağır metal analizleri; mikotoksin analizleri, fiziksel analizler ve taklit-tağşişe konu olabilecek bal, zeytinyağı gibi çok çok farklı ürün gruplarıyla ilgili çalışmalarımız oluyor. Öncelikle zehirlenme belirtileri; karın ağrısı, kusma, ishal, yüksek ateş, titreme, halsizlik, bitkinliktir. Bunların yanında daha ileri olarak sinir sisteminde bozukluklar olabilir. Ekstrem durumlarda felç ve ölümlere kadar gidebilir. Zehirlenmelere karşı hijyen çok önemli. Mümkünse açık ortamlardan ürünler almamalıyız. Özellikle sokakta satılan çiğ sütü tercih etmemeliyiz. Pastörize süt tercih etmeliyiz. Gıdalarımızı pişirirken mutlaka tam ve kusursuz bir şekilde 70 derecenin üzerinde homojen bir şekilde pişirmeliyiz. Eğer gıdayı o anda tüketmeyeceksek saklama koşullarımız mutlaka 10 derecenin altı veya 60 derecenin üstünde olmalı. El yüz hijyenimize çok dikkat etmeliyiz” dedi.